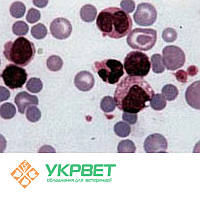
Тест-система для виявлення інфекційної анемії коней (Equine Infectious Anemia)

- Товари і послуги
- Новинки
- УЗД прилади
- Діагностика
- Свинарство
- Скотарство
- Конярство
- Вівчарство
- Птахівництво
- Кролівництво
- Ветеринарні препарати
- Тест-системи, набори ІФА та реагенти
- Лабораторія
- Показники біобезпеки
- Хірургія
- Дезінфекція
- Взуття та спецодяг
- Захист від гризунів і комах
- Витратні матеріали для медичних установ
- Зоотовари
- Маркування та ідентифікація тварин
- Голки та шприци
- Лампи для обігріву тварин
- Термометри
- Кормові добавки
- Оптимізовані системи роботи
- Вентиляція
- Розпродаж
- Новини
- Статті
- Про нас
- Відгуки
- Доставка і оплата
Фільтри
Контакти
+380 (68) 622-10-10
+380 (73) 426-45-45
+380 (50) 426-45-45
ІФА тест-системи
-
0301-0323
Тест-система для виявлення інфекційної анемії коней (Equine Infectious Anemia)Ціну уточнюйтеВ наявності
Тест-система для виявлення інфекційної анемії коней (Equine Infectious Anemia)Ціну уточнюйтеВ наявності -
0301-0324
 Тест-система для виявлення вірусного артеріїту коней (Equine Viral Arteritis)Ціну уточнюйтеВ наявності
Тест-система для виявлення вірусного артеріїту коней (Equine Viral Arteritis)Ціну уточнюйтеВ наявності -
0301-0326

-
0301-0302

